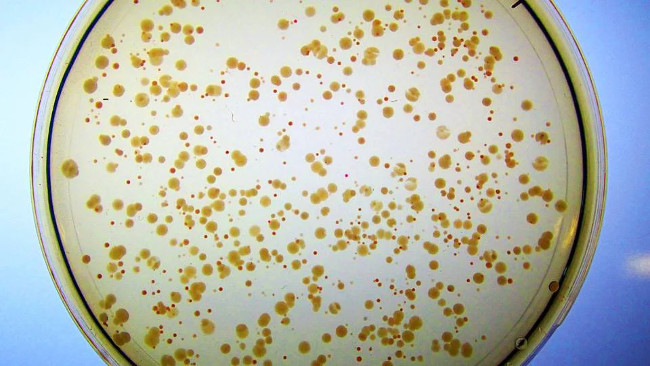

Một nghiên cứu mới từ đội Princeton đã mang lại một bước tiến lớn cho tương laibằng cách khẳng định rằng một protein nhân tạo mà nhóm nghiên cứu phát triển có thể hoạt động như một enzyme trong vi khuẩn sống.
Qua nhiều năm, đội Princeton đã tạo ra các protein nhân tạo cho E. coli, một loại vi khuẩn đơn giản thường được sử dụng như một thử nghiệm lâm sàng trong y học. Để kiểm tra tính khả quan của công trình, các nhà nghiên cứu đã loại bỏ một số gen có thể dẫn tới việc vi khuẩn không thể tạo ra enzyme Fes, mà các tế bào sử dụng để thu được sắt. Nếu không có chất khoáng quan trọng đó, vi khuẩn sẽ không thể tồn tại, nhưng nhóm nghiên cứu sau đó đã cấy các protein nhân tạo có thế thay thế chức năng bị mất để "cứu sống" hoặc hồi sinh vi khuẩn.
Trong nghiên cứu mới này, các nhà nghiên cứu đã xác định được cách mà các protein mới hoạt động. Họ phát hiện ra rằng hai trong số chúng cứu sống E. Coli bằng cách bù lại các enzyme bị mất, có thể thúc đẩy sản xuất các quá trình khác trong tế bào.
Ann Donnelly, tác giả chính của nghiên cứu cho biết: "Protein nhân tạo này có tên khoa học là Syn-F4, thực sự là một enzyme”.
Một enzyme nhân tạo như Syn-F4 là một bước quan trọng để phát triển thí nghiệm sinh học tổng hợp. Không những các dạng sống này có thể được thiết kế để phát triển thức ăn, nhiên liệu và thuốc một cách hiệu quả, mà chúng còn có thể giúp chúng ta hiểu cuộc sống có thể phát sinh như thế nào trong những hoàn cảnh khác - ví dụ như trên các hành tinh khác...
Hecht nói: "Chúng tôi đã giải thoát được 0,1% bộ gen E. coli. Cho đến bây giờ, nó là một E. coli kỳ lạ, chứa một số gen nhân tạo cho phép vi khuẩn dễ dàng phát triển. Không những thế, các chuyên gia đưa ra giả định rằng, nếu lượng enzyme nhân tạo thay thế lên tới tỉ lệ 10-20% hoạt động thành công thì E. coli này không còn kỳ lạ nữa mà nó trở thành một sinh vật mới.
Nghiên cứu này vừa được công bố trên tạp chí Nature Chemical Biology.
Xem thêm:
Hướng dẫn AI
Học IT
AI
Hàm Excel